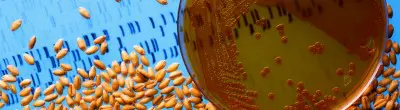
USDA GMO wheat

Now that spring has finally arrived, I thought it would be a good time to reflect on my first winter working at Farm Aid. Even though it hasn’t been that cold or snowy here in Massachusetts, my job has still felt different than it does at other times of year. Heading into December, I wondered what our hotline would be like for the next few months:
- Would more farmers be calling because they had time out of the fields?
- Would they be worrying about how to pay for their startup costs for next season?
- Would they be affected by winter storms across the southeast?
In some ways, it has been different.
A Look at the Numbers
I’ve received about 30% more calls from farmers in these past four months than I do at other times of year. For farmers who lost their fall harvest due to natural disasters, like the farmers I’ve worked with in South Carolina, they’re wondering how to pay back their operating loans and get the credit they need for this season.
When a farmer calls, I can be confident that I am referring them to high-quality resources and opportunities.
Meeting with Farmers
I’ve also been able to meet more farmers in person than I have at other times of year. Winter is meeting time for farmers. This is when organizations, like those that we fund, hold their annual meetings. For farmers, these meetings are the place to learn about new and innovative farming techniques and build community with other farmers. In January I traveled to Kentucky for the Southern Sustainable Agriculture Working Group (SSAWG) Conference, where I met farmers from all over the South. I was able to connect with farmers I’d talked with on the phone, but never met in person. I recently returned from a trip to Wisconsin for the Midwest Organic and Sustainable Education Services (MOSES) Conference, the largest organic farming conference in the country. At both of these conferences I was able to go to incredible workshops on helping farmers access credit and manage risk, which have been really useful back in the office.
Some Farmer Calls Stay the Same
But calls from poultry growers in the Southeast remind me that for them, the winter months aren’t much different than other months of the year. And so, despite the higher number of calls and more traveling to conferences, my days in the office are remarkably similar to other times of year. I’ve been working with a dairy farmer in Louisiana who needs to refinance a loan; a farmer in Pennsylvania trying to stop fracking near her farm; and an oyster farmer in New York trying to help other veterans start oyster farming.
Perhaps the biggest difference about this winter is that I have now been at Farm Aid for eight months. And with each month I have gotten better at understanding the issues facing farmers and the resources that are out there. So, when a farmer calls, I can be confident that I am referring them to high-quality resources and opportunities that address their issues and empower them to thrive. With spring upon us, I look forward to experiencing the work flow of a new season and supporting farmers with the unique challenges of getting back in the field.